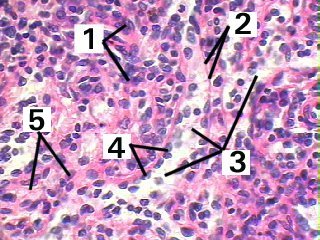
Fig 64-003

2. Fibers
3. Sinusoids
4. Endothelial cell nuclei
5. Parenchyme
| Fig 64-003 | |
|---|---|
| A very high magnification of the red pulp of the spleen demonstrating the different structures. | |
|
1. Cord of Billroth 2. Fibers 3. Sinusoids 4. Endothelial cell nuclei 5. Parenchyme |
© junie mm marius loots